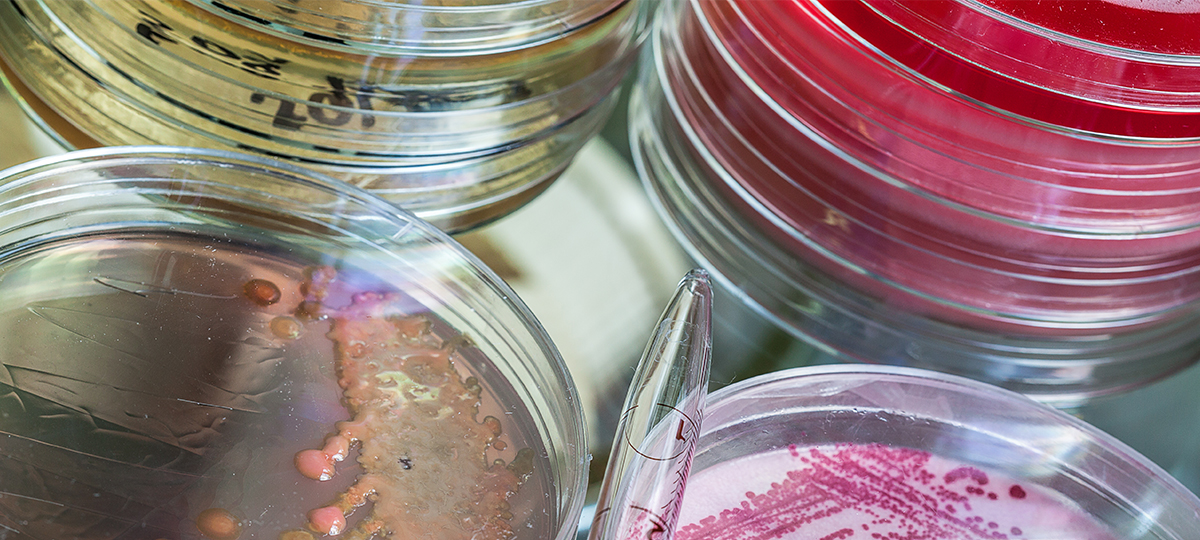

Trending
|
Eureka Staff
A Nasal Weapon, How Brexit Affects Science (Abstract Science: July 25-29)
Trump vs. Clinton on science, digging into our noses for antibiotics, and the science uncertainty after Brexit.
Trump vs. Clinton on Science
(Nature, 7/26/2016, Jeff Tollefson)
Though neither Republican Donald Trump nor Democrat Hillary Clinton has emphasized core research issues, the candidates — and their parties — are beginning to flesh out their positions on climate change, education, biomedical research and other topics that involve the scientific community. Deciphering Trump's views on core science issues has been difficult given the free-wheeling style of his populist campaign. He has often seemed to focus more on taunting the political establishment than on staking out policy positions. By contrast, the Clinton campaign has consulted dozens of scientists on topics that include health, education and the environment.
The Nose Knows an Antibiotic
(Science, 7/27/2016, Kai Kupferschmidt)
The dire need for new antibiotics to fight drug-resistant infections received a bit of a lift this week when researchers from the University of Tübingen in Germany synthesized an antibiotic by using one species of nose-producing bacteria to kill another microbe. The findings appear this week in the journal Nature. The discovery came from a project looking at why only a third of us harbor the relatively common Staphylococcus aureus in our noses. A snot analysis—really!—found that the nose is actually a kind of desert environment, unfriendly to bacteria. Bacteria must compete aggressively to survive, and it turns out that one species of staph, S. lugdunensis, does so by producing an antibiotic compound that prevents S. aureus from growing.
Science Uncertainty after Brexit
(Science, 7/27/2016, Erik Stokstad)
In the weeks since the United Kingdom voted to leave the European Union, the U.K. government has made it clear that foreign residents won't be kicked out, and their legal rights remain intact—and that might only change after new treaties are forged, a process that could take years. But when the University of Oxford in the United Kingdom held an information session on Brexit this month, the meeting was packed and several hundred scientists and other staff crammed into an overflow room. "The general feeling was anxiety," says Ian Walmsley, pro-vice-chancellor for research and innovation at Oxford.
—Compiled by Senior Scientific Writer Regina McEnery




